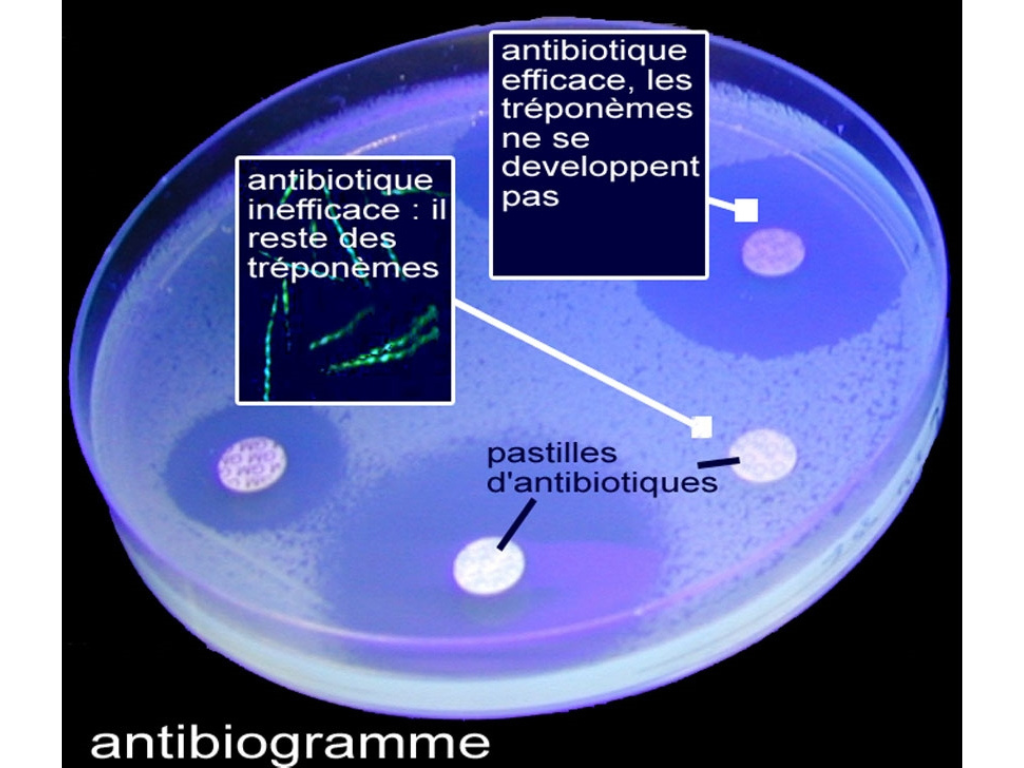

Les traitements de la syphilis
Une maladie qui se traite bien aujourd'hui
L'avènement de la pénicilline a révolutionné le pronostic de la syphilis et a expliqué son éradication au cours du siècle dernier. La recrudescence des cas actuellement observés se traite facilement par injection de pénicilline retard avec une efficacité de 100%.
Le traitement de la syphilis repose sur la prescription d'un antibiotique, la pénicilline, et plus précisément d'une forme spécifique de pénicilline, la benzathine pénicilline G retard à raison d'une injection intramusculaire unique de 2,4 millions d'unités dans les cas de syphilis précoce.
En cas de syphilis tertiaire non neurologique ou de syphilis latente tardive, il est nécessaire de pratiquer une injection par semaine pendant 3 semaines. En cas de neurosyphilis, une hospitalisation est nécessaire avec une perfusion intraveineuse de 20 millions d'unités par jour de pénicilline G pendant 14 jours. L'efficacité de ce traitement est de 100%.
En cas d'allergie à la pénicilline, on peut administrer un autre antibiotique de la famille des tétracyclines, la doxycycline, 200 mg/jour par voie orale, pendant 15 jours s'il s'agit d'une syphilis précoce et pendant 28 jours s'il s'agit d'une syphilis tardive non neurologique. En cas de neurosyphilis, il n'y a pas d'alternative thérapeutique à la pénicilline. Il est alors possible d'induire une tolérance à la pénicilline en administrant de petites doses de pénicilline quelques jours avant le traitement.
Réaction paradoxale
En cas de syphilis secondaire avec de nombreuses lésions, il peut se produire une réaction paradoxale ou réaction d'Herxheimer, survenant quelques heures (4 à 6 heures) après l'injection et consistant en une aggravation transitoire de ces dernières.
Surveillance
Il est conseillé de revoir le médecin 10 à 15 jours après l'injection, puis 6 mois et 1 an plus tard afin de faire une sérologie VDRL de contrôle qui doit se négativer, témoignant ainsi de la guérison. Il faut compter environ 1 an pour la négativation de la sérologie VDRL en cas de syphilis primaire et environ 2 ans en cas de syphilis secondaire.
Conseils contre la syphilis
Des solutions lorsque ça gratte !
Le préservatif est le seul moyen de prévention efficace
En raison de sa très grande facilité de transmission au contact d'un chancre syphilitique, le port du préservatif est la seule prévention réellement efficace. Le dépistage d'autres infections sexuellement transmissibles doit être systématique.
La syphilis est une infection qui se transmet facilement au contact d'un chancre. L'utilisation du préservatif est le seul moyen de prévention efficace. Cette infection ne transfère aucune immunité, c'est-à-dire aucune protection pour l'avenir. On peut se contaminer à nouveau, et il faut donc se protéger efficacement et systématiquement.
Penser au dépistage d'autres infections sexuellement transmissibles
Avoir contracté une syphilis doit faire évoquer la possibilité d'une contamination par une autre infection sexuellement transmissible comme le VIH, l'hépatite B, des chlamydiae… Des examens complémentaires comme des prélèvements sanguins ou gynécologiques peuvent être nécessaires.